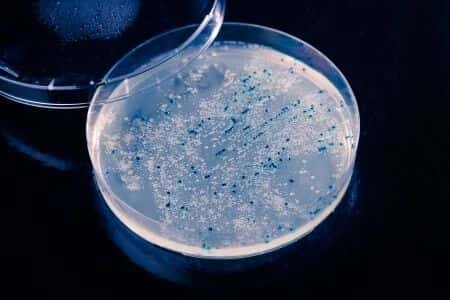
Leading Neurologist Opines on Nerve Damage From Toxic Mold Exposure

Leading Neurologist Opines on Nerve Damage From Toxic Mold Exposure
Updated on
Case Overview
This case involves a man who suffered a number of neurological symptoms after he was exposed to toxic mold in his apartment, which was already plagued with issues of pest infestation and mismanagement. Unbeknownst to the Plaintiff, the apartment he had lived in for several years was heavily infested with black mold after a pipe break incident caused serious water damage to the walls and floor. During his time in the apartment, the man began experiencing progressively worsening neurological symptoms, including memory loss, headaches, and eventually seizures. On one occasion, the man suffered a major seizure while at home, causing him to fall down the stairs and suffer serious injuries. It was alleged that the damage to the man’s nervous system was caused by exposure to neurotoxins released by the mold infestation.
Questions to the Neurology expert and their responses
Do you have extensive experience examining/ treating patient suffering from mold exposure?
Mold exposure is unusual. I have seen a handful (less than 5) patients with neurologic sequelae to Mold exposure.
What kind of complications can occur from mold exposure over a long period of time?
I can only speak to neurologic complications, but the cases that I have (documented to have a Mold exposure) include seizure, headaches, and demyelination; including both central demyelination (looks like Multiple Sclerosis clinically) and another that is peripheral (Chronic Demyelinating Polyneuropathy).
What kind symptoms can exposure to mold biotoxins and neurotoxins present?
Neurologic symptoms include confusion, dizziness, weakness, gait abnormality, seizures, headaches, ataxia, and nystagmus, and it is certainly possible that the symptoms exhibited by the Plaintiff in this case are the result of toxic mold exposure.
About the expert
This board certified expert earned his bachelor's degree from Fordham University and his MD from SUNY Upstate Medical University. He completed an internship and a residency in neurology at the SUNY Upstate Medical University. This expert is a member of numerous prestigious medical societies and has earned numerous awards for his contributions as a physician. He currently serves as a neurologist at a private practice.
E-001495
Specialties:
Subscribe to our newsletter
Join our newsletter to stay up to date on legal news, insights and product updates from Expert Institute.
Sign up nowFind an expert witness near you
What State is your case in?
Subscribe to our newsletter
Join our newsletter to stay up to date on legal news, insights and product updates from Expert Institute.